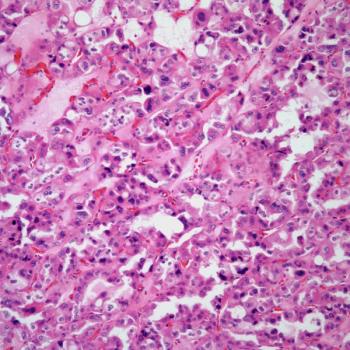
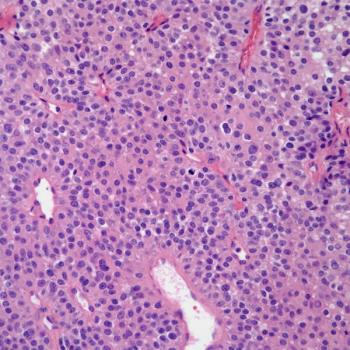

A 25-year-old man presents with neck pain. Imaging detects a mass in the thyroid gland, and a biopsy is performed. What is your diagnosis?

A 25-year-old man presents with neck pain. Imaging detects a mass in the thyroid gland, and a biopsy is performed. What is your diagnosis?

A 53-year-old woman presents with a lesion in the right breast, and a biopsy is performed. What is your diagnosis?

A 33-year-old man presents with pain in his right calf, and a biopsy is performed. What’s your diagnosis?

A 53-year-old man presents with a mass behind his right knee, and a biopsy is performed. What is your diagnosis?

A 47-year-old woman presents with a posterior mediastinal mass, and a biopsy is performed. What is your diagnosis?

A 59-year-old woman presents with a purplish lesion on her left buttock, and a biopsy is performed. What is your diagnosis?

A 48-year-old man presents with pain in the left leg, and a biopsy is performed. What is your diagnosis?

A 43-year-old man presents with a retroperitoneal mass, and a biopsy is performed. What is your diagnosis?

A 37-year-old immunosuppressed man presents with a lesion on his right upper shoulder, and a biopsy is performed.

A 45-year-old woman presents with an anterior mediastinal mass, and a biopsy is performed. What is your diagnosis?

A 45-year-old woman presents with a vulvar lesion, and a biopsy is performed. What is your diagnosis?

A 39-year-old man presents with a soft-tissue lesion in the wrist. What is your diagnosis?

A prostate biopsy from a 62-year-old man is shown. What is your diagnosis?

A 68-year-old woman presents with abdominal pain and hematuria, and a biopsy is performed. What is your diagnosis?

A 39-year-old woman presents with enlarged lymph nodes, and a biopsy is performed. What is your diagnosis?

A 68-year-old man presents with a cough and chest pain. Chest imaging shows a lung mass in the right upper lobe. What is your diagnosis?

A 52-year-old man presents with lower abdominal pain and bloody stools. A colon biopsy is obtained. What is your diagnosis?
A 54-year-old woman presents with hematuria and pain. A kidney mass is found on imaging, and a biopsy is performed. What is your diagnosis?

A 35-year-old immunosuppressed man presents with abdominal pain, and a gastric biopsy is obtained. What is your diagnosis?

A 32-year-old woman presents with a lump in her right breast, and a biopsy is performed. What is your diagnosis?

A 43-year-old man presents with an anterior mediastinal mass, and a biopsy is performed. What is your diagnosis?
A 58-year-old man presents with a mass on the right side of his neck. What is your diagnosis?

A 30-year-old man presents to the emergency with severe abdominal pain. An appendectomy is performed. What is your diagnosis?

A 47-year-old man presents with shortness of breath and is found to have an anterior mediastinal mass. A biopsy is performed. What is your diagnosis?

A 57-year-old man presents with swelling of the scrotum. What is your diagnosis?

A 43-year-old man presents with a right thigh mass, and a biopsy is performed. What is your diagnosis?

A 47-year-old man presents with nausea and vomiting. A gastric biopsy is obtained. What is your diagnosis?

A 73-year-old man presents with congestive heart failure and a cardiac biopsy is performed. What is your diagnosis?

A 12-year-old boy is found to have an abdominal mass and a biopsy is performed. What is your diagnosis?

A vaginal mass is discovered in a 29-year-old woman. A biopsy is performed. What is your diagnosis?